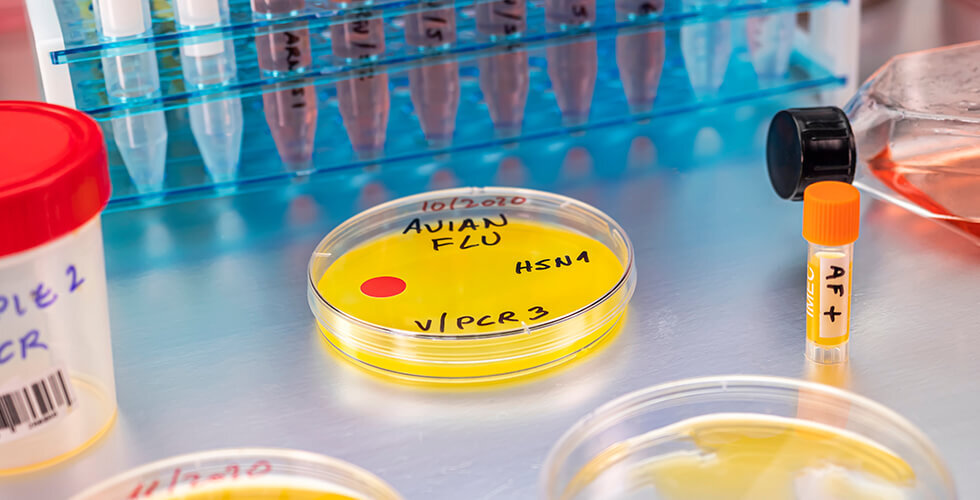

Days before President-elect Trump takes office, the Biden administration has announced a $500 million security package for Ukraine. Defense Secretary Lloyd Austin, meeting with Ukrainian President Volodymyr Zelenskyy in Germany, emphasized the need to support Ukraine against Russian aggression. The package includes missiles, F-16 equipment, and other military supplies sourced from U.S. stockpiles for expedited delivery.
Senators Push for Permanent Daylight Saving Time

Sen. Rick Scott reintroduced a bipartisan bill to make daylight saving time permanent, eliminating the biannual clock changes. The proposed legislation, supported by several senators, aims to extend brighter evenings year-round, addressing public frustration and economic and health impacts. Scott expressed optimism about the bill’s passage with backing from the incoming Trump administration.
Celebrity Homes Destroyed in LA Fires

Wildfires in Los Angeles have devastated celebrity neighborhoods, destroying homes of figures like Billy Crystal, Mandy Moore, and Paris Hilton. Over 1,900 structures are gone, with tens of thousands displaced. Crystal and Moore shared emotional statements about their losses, emphasizing resilience and community rebuilding. The fires have also disrupted Hollywood’s award season, postponing events and delaying Oscar nominations.
Alleged Japan Mobster Pleads Guilty to Selling Nukes

Takeshi Ebisawa, an alleged Yakuza leader, admitted to trafficking weapons-grade nuclear materials and orchestrating narcotics and weapons deals. Investigated by the DEA, Ebisawa attempted to sell uranium and plutonium from Myanmar to a supposed Iranian general and planned to distribute heroin and methamphetamine in the U.S. Ebisawa’s guilty plea underscores the international scope of his crimes, including laundering money and purchasing U.S.-made missiles.
First U.S. Human Death from Bird Flu Reported
The first U.S. human death from bird flu has been reported in Louisiana. The patient, over 65 years old with underlying health conditions, was hospitalized after exposure to infected backyard poultry and wild birds. This marks the first severe U.S. case of H5N1 avian influenza. Health officials emphasize that the risk to the general public remains low, with no evidence of person-to-person transmission.




